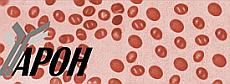
Image

Diagnose: Wie wird eine angeborene Kugelzellenanämie festgestellt?
Autor: Prof. Dr. med. Stefan Eber, Zuletzt geändert: 27.08.2025 https://kinderblutkrankheiten.de/doi/e285910
Es gibt es keinen einzelnen "beweisenden" Test für die angeborene Kugelzellenanämie. Die Diagnose sollte von Spezialisten für Bluterkrankungen bei Kindern und Jugendlichen (pädiatrischen Hämatologen) anhand mehrerer Faktoren wie Krankengeschichte, Krankheitszeichen und Blutwerten gestellt beziehungsweise ausgeschlossen werden.
Besteht bei einem Kind aufgrund der Krankengeschichte (Anamnese), der körperlichen Untersuchung und der Krankheitszeichen der Verdacht auf die Erkrankung, und kommt diese innerhalb der Familie des Kindes bereits vor (positive Familienanamnese), reicht folgendes für die Diagnosestellung meist aus: der alleinige Nachweis einer erniedrigten Konzentration des roten Blutfarbstoffs (Hämoglobin) in den Erythrozyten (erniedrigte Hämoglobinkonzentration,) sowie der Nachweis eines gesteigerten Blutzerfalls und der Ausschluss anderer Ursachen der Blutarmut.
Hingegen muss die Diagnose bei Patienten ohne eine positive Familienanamnese grundsätzlich auf mehreren Blutuntersuchungen beruhen. Zu diesen Untersuchungen gehören beispielsweise
- die Bestimmung der Konzentration von Hämoglobinabbauprodukten (Bilirubin) im Blut,
- die Bestimmung der Anzahl "junger" roter Blutkörperchen (Retikulozyten) im Blut,
- der Nachweis von Kugelzellen im Blutausstrich,
- die Prüfung der Stabilität der Erythrozytenwände (osmotische Fragilitätsprüfung),
- die Bestimmung von Antikörpern gegen rote Blutkörperchen (Coombs-Test),
- eventuell molekulargenetische Untersuchungen zur Identifizierung der Vererbungsform.
Hinzu kommt, dass es zahlreiche andere angeborene und erworbene Formen der Blutarmut gibt, die ähnlich wie eine Kugelzellenanämie verlaufen. Zu diesen Erkrankungen gehören andere Erythrozytenwanddefekte wie die Elliptozytose oder die Poikilozytose, sowie Krankheiten, bei denen bestimmte Botenstoffe in den roten Blutkörperchen nicht richtig funktionieren (Erythrozytenenzymdefekte) wie der Pyruvatkinasemangel, oder auch eine gestörte Erythrozytenproduktion, oder ein gesteigerter Verlust von roten Blutkörperchen als Folge von Gefäßschädigungen oder bestimmten Infektionen.
Des Weiteren können Kugelzellen in verschiedenen Situationen (bei Verbrennungen, nach einem Schlangenbiss oder im Rahmen bestimmter Infektionen) vorübergehend auch im Blut von Kindern vorkommen, die keine angeborene Kugelzellenanämie haben. Alle diese Erkrankungen müssen ausgeschlossen werden, bevor die Diagnose der angeborenen Kugelzellenanämie gestellt werden darf.
Weitere Blutentnahmen und Untersuchungen sind notwendig, wenn es zu gesundheitlichen Problemen im Rahmen der Erkrankung kommt oder auch, um diesen vorzubeugen. Zu diesen Maßnahmen gehören beispielsweise:
- regelmäßige körperliche Untersuchungen im Spezialzentrum/hämatologischen Spezialisten,
- Bestimmung der Blutgruppe zur Vorbereitung von Bluttransfusionen,
- Bestimmung der Konzentrationen von Hämoglobin und seinem Abbauprodukt Bilirubin sowie der Zahl der jungen und reifen roten Blutkörperchen bei Zeichen der Blutarmut,
- Bestimmung der Konzentration von Speichereisen (SerumFerritin) für das rechtzeitige Erkennen einer Eisenüberladung,
- Ultraschalluntersuchungen des Bauchraums zur Kontrolle der Milzgröße, zum Erkennen von Gallensteinen, zur Vorbereitung von Operationen (Entfernung der Gallenblase, Entfernung der Milz)
Anmerkung: Nicht alle Untersuchungen sind bei jedem Patienten notwendig. Vorgeburtliche Untersuchungen sind nicht angezeigt. Ihr Behandlungsteam wird Sie darüber informieren, welche diagnostischen Verfahren bei Ihrem Kind jeweils erforderlich sind.